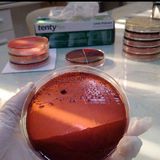

Other commentsSign in to post comments. You don't have an account? Sign up now!
Is there still a need to blow add in? Or continuous compression will do also
almost 8 years ago
If the victim is unresponsive tell someone to call 911 first thing to do not last thing
about 7 years ago
Normally when we are taught, they say. 1: stop the accident/asess the scene. 2: check for consciousness and breathing. 3: if the person is unconscious, and/or with irregular breathing, call for help 912 (112 in denmark). 4: perform CPR.